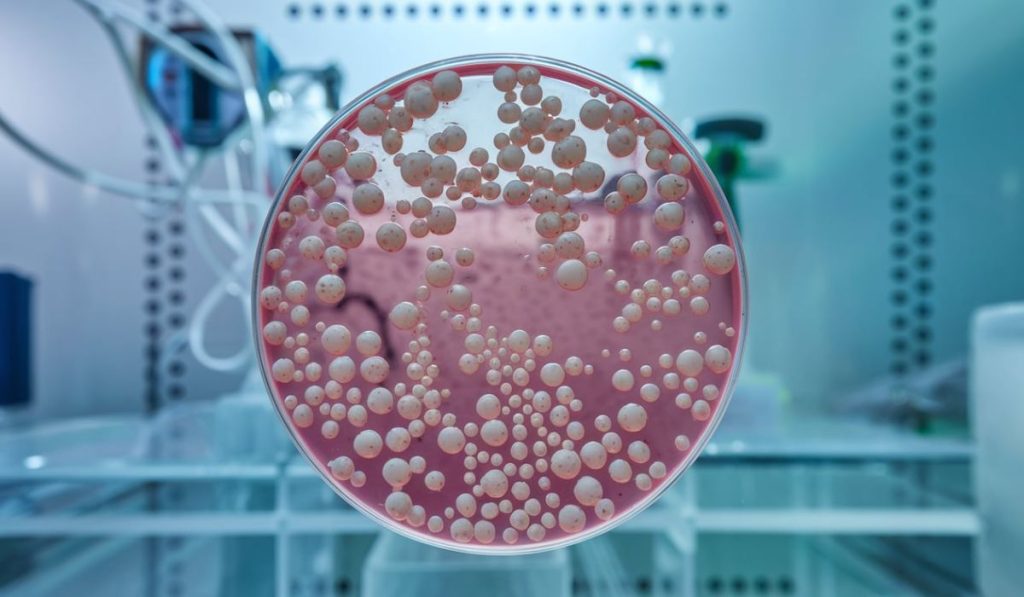

Have you ever heard of ? If not, you’re not alone. These fascinating cells play a critical role in science and medicine, and yet they often fly under the radar. Let’s dive in and explore what are, why they matter, and how they’ve shaped advancements in research and healthcare.
Introduction to Vero Cells
So, what are Vero cells? Simply put, they’re a type of cell line derived from the kidney of an African green monkey. These cells are used extensively in scientific research and vaccine production. Think of them as a kind of “workbench” where scientists can study viruses, bacteria, and other microbes safely and effectively.
Origin of Vero Cells

The story of Vero begins in 1962 in Japan. Researchers extracted kidney cells from an African green monkey (Chlorocebus sabaeus) and cultured them in a lab. The name “Vero” comes from “Verda Reno,” which is Esperanto for “green kidney.” Fascinating, right?
How Are Vero Cells Cultured?
Culturing what are vero cells growing them in a controlled environment with the right nutrients. Think of it like gardening—you provide water, sunlight, and soil for plants to grow. For cells, scientists use a nutrient-rich liquid called a culture medium and maintain the cells in a temperature-controlled incubator.
Why Are Vero Cells Important?
Why all the fuss about these cells? Well, they’re highly versatile and can grow viruses and bacteria that infect humans, which is crucial for studying diseases. Unlike some human cells, don’t produce interferon, a protein that can block viral replication. This makes them ideal for growing viruses in a lab setting.
Role of Vero Cells in Vaccines
When it comes to vaccine production, are like unsung heroes. They’ve been used to produce vaccines for diseases like polio, rabies, and even COVID-19. By growing viruses in these cells, scientists can weaken or inactivate the pathogens, making them safe for use in vaccines.
Applications Beyond Vaccines
aren’t just for vaccines. They’re also used to study cancer, test the safety of new drugs, and even develop treatments for rare diseases. Their adaptability makes them a cornerstone of medical research.
Are Vero Cells Safe to Use?
Yes, cells are considered safe for use in research and medicine. Before any product reaches the public, it undergoes rigorous testing to ensure it meets safety standards. Scientists have been using these cells for decades, and their track record speaks for itself.
Ethical Considerations
Using cells derived from animals often raises ethical questions. However, it’s important to note that cells have been cultured in labs for over 60 years, meaning no additional animals are involved. Researchers strive to minimize ethical concerns while advancing science.
Common Misconceptions
There are plenty of myths about . Some people think they’re directly injected into vaccines or that they pose health risks. In reality, are just a tool to grow viruses or bacteria, not an ingredient in the final vaccine.
Future of Vero Cells in Research

The future looks bright for . With advances in biotechnology, scientists are exploring new ways to use these cells, from developing personalized medicine to studying emerging infectious diseases. It’s like unlocking new levels in a video game of medical discovery.
Conclusion: Why Vero Cells Matter
In summary, are a vital part of modern science. They help us understand diseases, develop vaccines, and test new treatments safely. Whether it’s combating pandemics or curing rare conditions, these cells play a starring role in shaping a healthier world.
FAQs About Vero Cells
1. What are Vero cells used for?
Vero are used to grow viruses, test drugs, and produce vaccines. They’re essential in studying infectious diseases and medical treatments.
2. Are Vero cells safe for humans?
Yes, they’re extensively tested for safety and are not directly introduced into the human body. They’re used to prepare safe medical products.
3. Why are Vero cells used in vaccine production?
They can efficiently grow viruses needed to create vaccines, making them a reliable and scalable choice for researchers.
4. Do come from monkeys?
Originally, yes, but they’ve been cultured in labs for decades, so no additional animals are involved today.
5. Can Vero cells be replaced with other cell lines?
While other cell lines exist, remain a popular choice due to their unique properties and proven effectiveness.
For More Visit, realmeet





